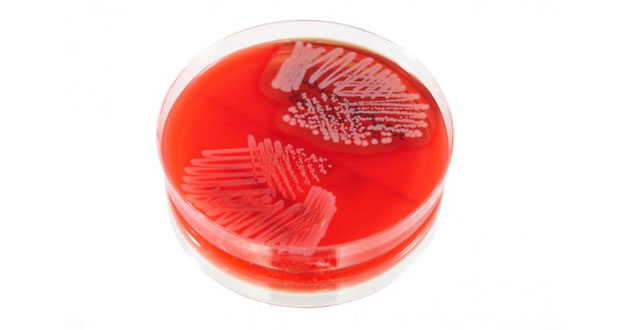
impetigo

Impetigo este o infecție a pielii care afectează în general părțile expuse ale corpului, în special fața, mâinile și genunchii. Ea apare cel mai frecvent la copii, deși uneori nici adulții nu sunt cruțați.
Primele simptome sunt sub formă de puncte roșii pe piele, care se transformă ulterior în pustule apoase. Acestea se sparg, lăsând în urmă răni gălbui, care prind crustă. Impetigo este o boală infecțioasă extrem de virulentă – curând vor apărea noi puncte și noi răni în jurul zonei inițiale de infecție. Dacă nu este tratată, boala poate dura câteva săptămâni.
Tratament

Trebuie, totodată, să spălați frecvent zona cu un antiseptic diluat cu apă călduță, pentru a limita infecția. Dacă bolnavul este un copil, trebuie să luați toate măsurile să nu își atingă și să nu își scarpine rănile. Spălați-i prosoapele, lenjeria și hainele separat de cele ale restului familiei.
Cu un tratament corect, impetigo trebuie să dispară în scurt timp.
